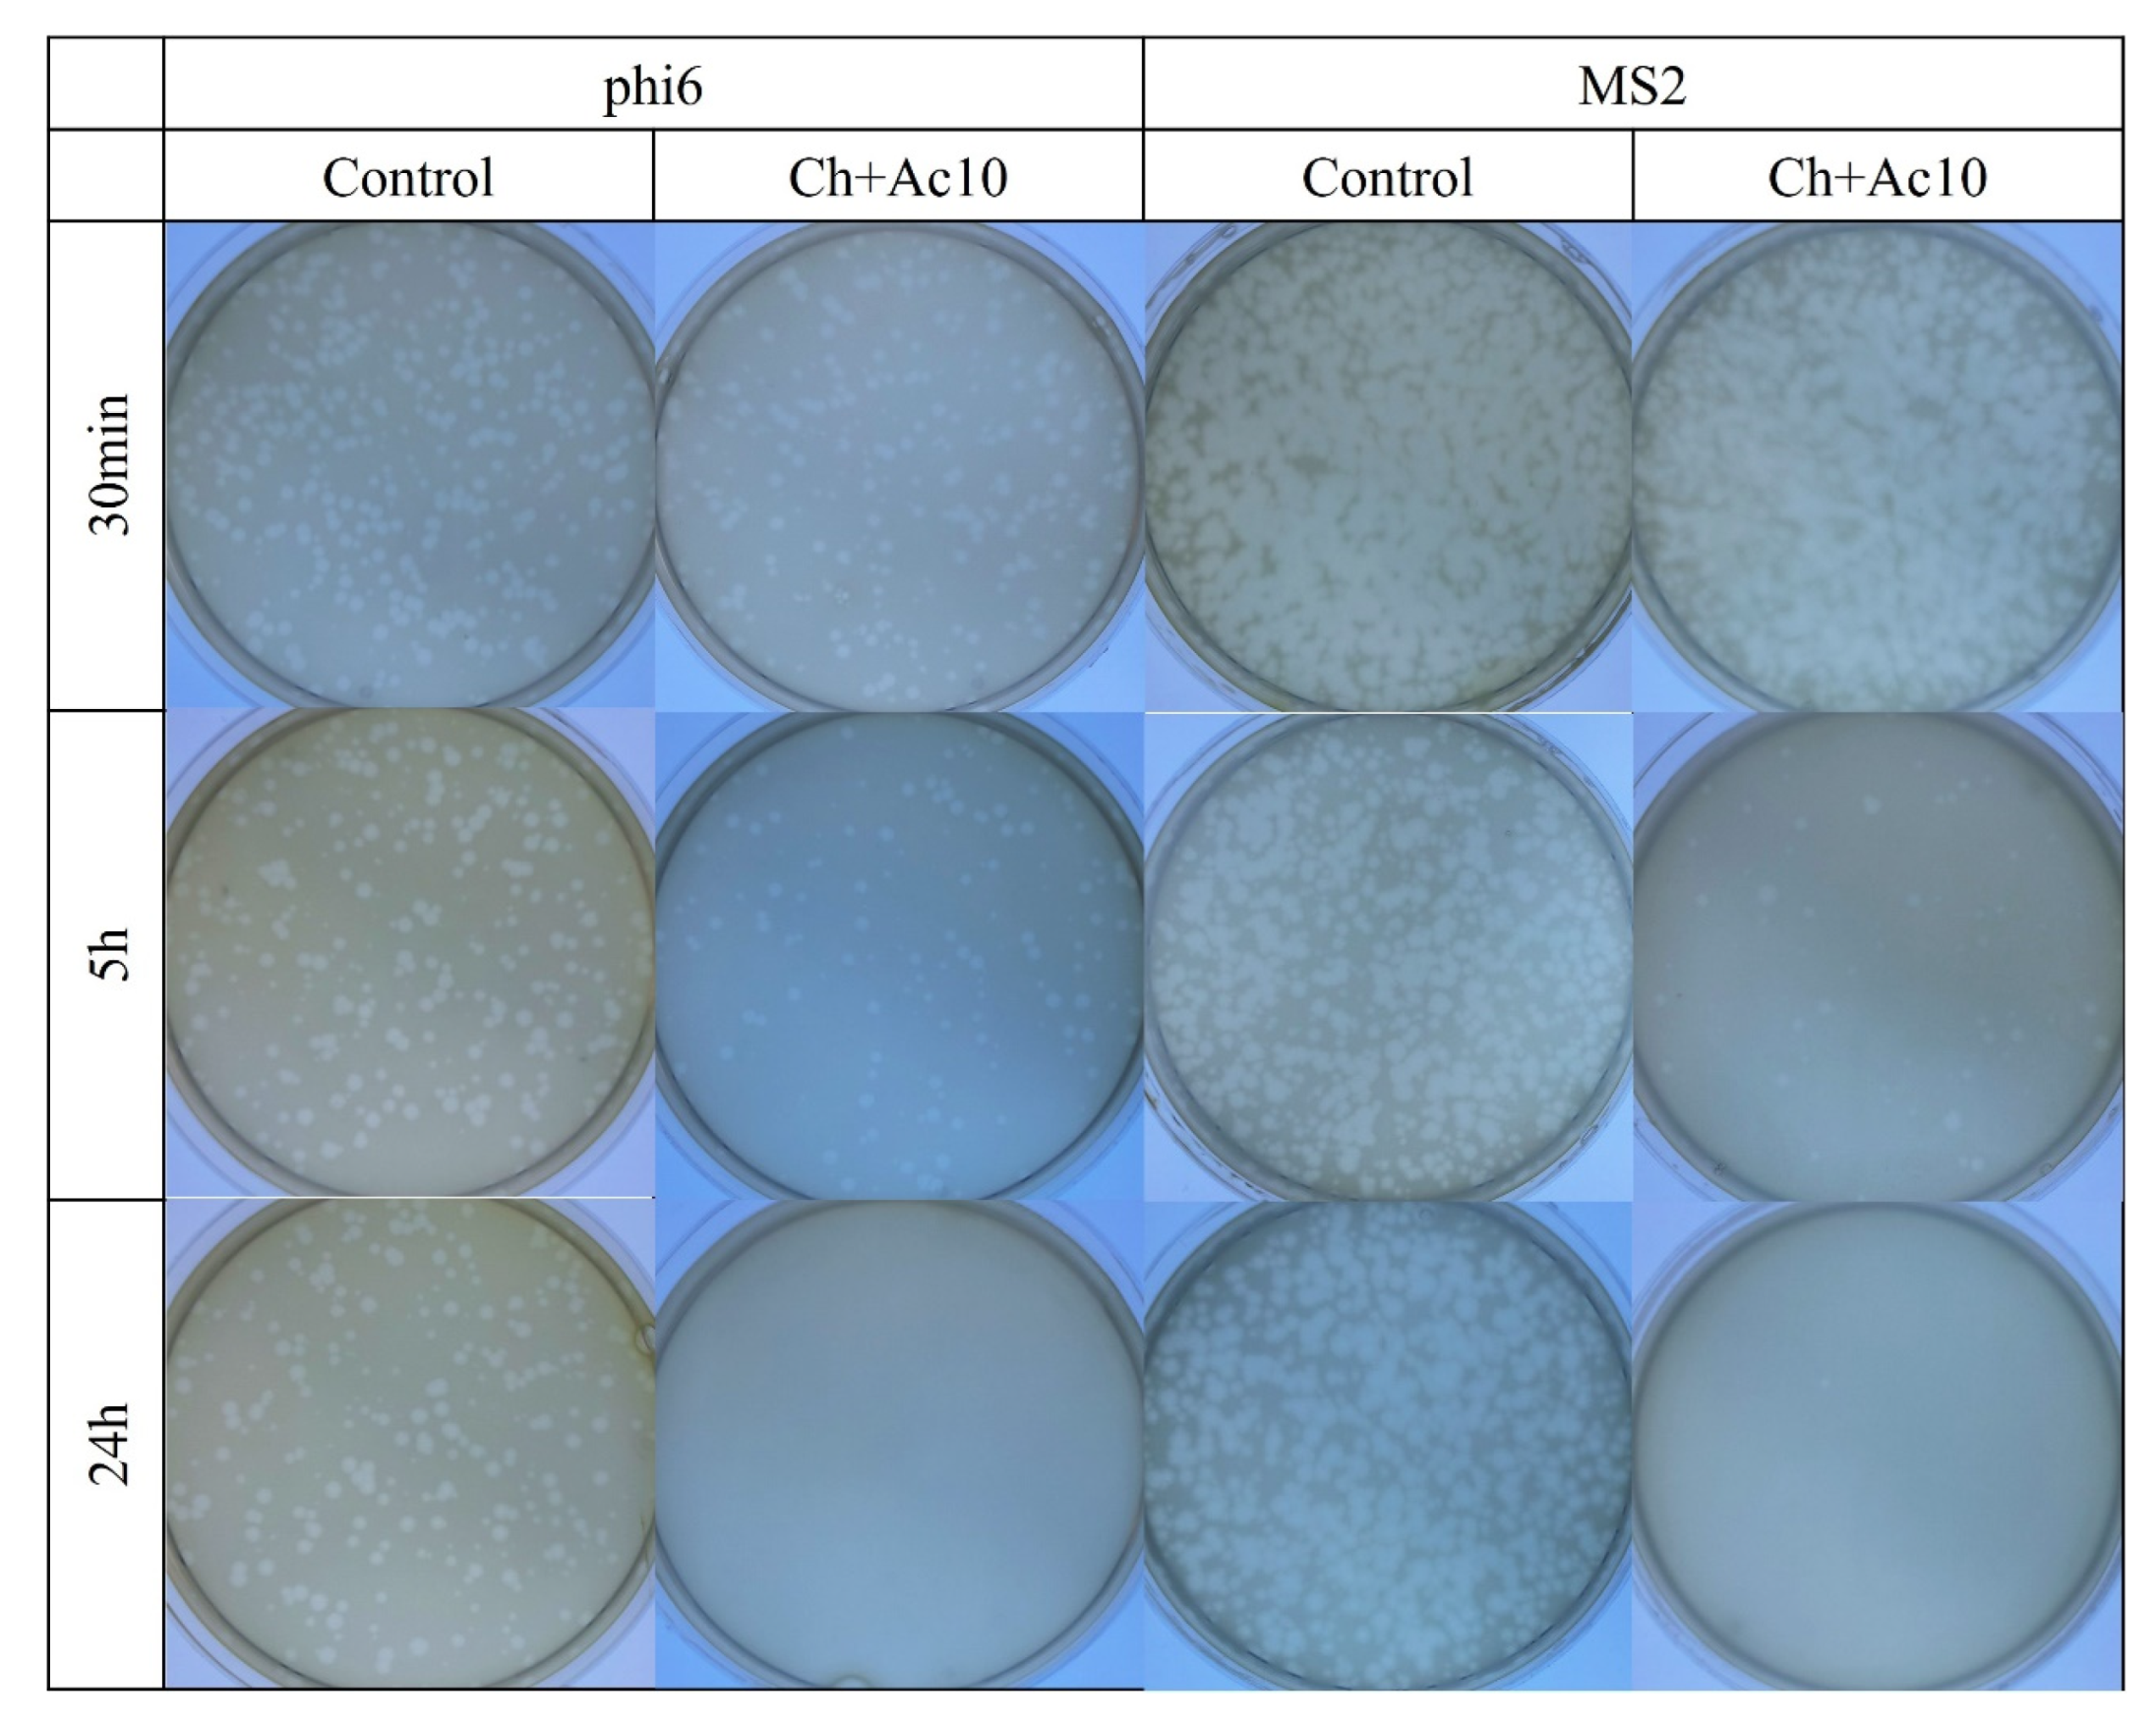
Ijms 24 12028 g002 Ijms 24 12028 g002

Biocompatible Chitosan Films Containing Acetic Acid Manifested Potent Antiviral Activity against Enveloped and Non-Enveloped Viruses
Abstract
1. Introduction
2. Results
2.1. Film Composition
2.2. Toxicological Study
2.3. Antiviral Test against Enveloped and Non-Enveloped Viruses
2.4. Double-Stranded RNA Extraction and Quantification
3. Discussion
4. Materials and Methods
4.1. Materials
4.2. Synthesis
4.3. Toxicological Study
4.4. Antiviral Test against Enveloped and Non-Enveloped Viruses
4.5. Double-Stranded RNA Extraction and Quantification
4.6. Statistical Analysis
5. Conclusions
Author Contributions
Funding
Institutional Review Board Statement
Informed Consent Statement
Data Availability Statement
Acknowledgments
Conflicts of Interest
References
- Felt, O.; Buri, P.; Gurny, R. Chitosan: A Unique Polysaccharide for Drug Delivery. Drug Dev. Ind. Pharm. 1998, 24, 979–993. [Google Scholar] [CrossRef]
- Muzzarelli, R.A. Biochemical significance of exogenous chitins and chitosans in animals and patients. Carbohydr. Polym. 1993, 20, 7–16. [Google Scholar] [CrossRef]
- Azad, A.K.; Sermsintham, N.; Chandrkrachang, S.; Stevens, W.F. Chitosan membrane as a wound-healing dressing: Characterization and clinical application. J. Biomed. Mater. Res. 2004, 69, 216–222. [Google Scholar] [CrossRef] [PubMed]
- Foster, L.J.R.; Ho, S.; Hook, J.; Basuki, M.; Marçal, H. Chitosan as a Biomaterial: Influence of Degree of Deacetylation on Its Physiochemical, Material and Biological Properties. PLoS ONE 2015, 10, e0135153. [Google Scholar] [CrossRef]
- Jia, Z.; Shen, D.; Xu, W. Synthesis and antibacterial activities of quaternary ammonium salt of chitosan. Carbohydr. Res. 2001, 333, 1–6. [Google Scholar] [CrossRef]
- Qi, L.; Xu, Z.; Jiang, X.; Hu, C.; Zou, X. Preparation and antibacterial activity of chitosan nanoparticles. Carbohydr. Res. 2004, 339, 2693–2700. [Google Scholar] [CrossRef]
- Pillai, C.K.S.; Paul, W.; Sharma, C.P. Chitin and chitosan polymers: Chemistry, solubility and fiber formation. Prog. Polym. Sci. 2009, 34, 641–678. [Google Scholar] [CrossRef]
- Rinaudo, M.; Pavlov, G.; Desbrières, J. Influence of acetic acid concentration on the solubilization of chitosan. Polymer 1999, 40, 7029–7032. [Google Scholar] [CrossRef]
- Amruta, N.; Maness, N.J.; Gressett, T.E.; Tsuchiya, Y.; Kishi, M.; Bix, G. Effect of acetic acid inactivation of SARS-CoV-2. PLoS ONE 2023, 18, e0276578. [Google Scholar] [CrossRef] [PubMed]
- Sharma, N.; Modak, C.; Singh, P.K.; Kumar, R.; Khatri, D.; Singh, S.B. Underscoring the immense potential of chitosan in fighting a wide spectrum of viruses: A plausible molecule against SARS-CoV-2? Int. J. Biol. Macromol. 2021, 179, 33–44. [Google Scholar] [CrossRef]
- Pospieszny, H.; Chirkov, S.; Atabekov, J. Induction of antiviral resistance in plants by chitosan. Plant Sci. 1991, 79, 63–68. [Google Scholar] [CrossRef]
- Iriti, M.; Sironi, M.; Gomarasca, S.; Casazza, A.; Soave, C.; Faoro, F. Cell death-mediated antiviral effect of chitosan in tobacco. Plant Physiol. Biochem. 2006, 44, 893–900. [Google Scholar] [CrossRef]
- Jaber, N.; Al-Remawi, M.; Al-Akayleh, F.; Al-Muhtaseb, N.; Al-Adham, I.S.I.; Collier, P.J. A review of the antiviral activity of Chitosan, including patented applications and its potential use against COVID-19. J. Appl. Microbiol. 2021, 132, 41–58. [Google Scholar] [CrossRef]
- Hassan, M.I.; Mohamed, A.F.; Taher, F.A.; Kamel, M.R. Antimicrobial Activities of Chitosan Nanoparticles Prepared from Lucilia Cuprina Maggots (Diptera: Calliphoridae). J. Egypt. Soc. Parasitol. 2016, 46, 563–570. [Google Scholar] [CrossRef]
- Rabea, E.I.; Badawy, M.E.-T.; Stevens, C.V.; Smagghe, G.; Steurbaut, W. Chitosan as Antimicrobial Agent: Applications and Mode of Action. Biomacromolecules 2003, 4, 1457–1465. [Google Scholar] [CrossRef]
- Serrano-Aroca, Á. Antiviral Characterization of Advanced Materials: Use of Bacteriophage Phi 6 as Surrogate of Enveloped Viruses Such as SARS-CoV-2. Int. J. Mol. Sci. 2022, 23, 5335. [Google Scholar] [CrossRef]
- Johnston, C.S.; Gaas, C.A. Vinegar: Medicinal uses and antiglycemic effect. MedGenMed Medscape Gen. Med. 2006, 8, 61. [Google Scholar]
- Zinn, M.-K.; Bockmühl, D. Did granny know best? Evaluating the antibacterial, antifungal and antiviral efficacy of acetic acid for home care procedures. BMC Microbiol. 2020, 20, 265. [Google Scholar] [CrossRef] [PubMed]
- Halstead, F.D.; Rauf, M.; Moiemen, N.S.; Bamford, A.; Wearn, C.M.; Fraise, A.P.; Lund, P.A.; Oppenheim, B.A.; Webber, M.A. The Antibacterial Activity of Acetic Acid against Biofilm-Producing Pathogens of Relevance to Burns Patients. PLoS ONE 2015, 10, e0136190. [Google Scholar] [CrossRef] [PubMed]
- Cerón, S.; North, B.J.; Taylor, S.A.; Leib, D.A. The STING agonist 5,6-dimethylxanthenone-4-acetic acid (DMXAA) stimulates an antiviral state and protects mice against herpes simplex virus-induced neurological disease. Virology 2019, 529, 23–28. [Google Scholar] [CrossRef] [PubMed]
- Shirey, K.A.; Nhu, Q.M.; Yim, K.C.; Roberts, Z.J.; Teijaro, J.R.; Farber, D.L.; Blanco, J.C.; Vogel, S.N. The anti-tumor agent, 5,6-dimethylxanthenone-4-acetic acid (DMXAA), induces IFN-β-mediated antiviral activity in vitro and in vivo. J. Leukoc. Biol. 2010, 89, 351–357. [Google Scholar] [CrossRef]
- Pianta, L.; Vinciguerra, A.; Bertazzoni, G.; Morello, R.; Mangiatordi, F.; Lund, V.J.; Trimarchi, M. Acetic acid disinfection as a potential adjunctive therapy for non-severe COVID-19. Eur. Arch. Oto-Rhino-Laryngol. 2020, 277, 2921–2924. [Google Scholar] [CrossRef]
- Romero, J.A.F.; Alonso, G.d.B.; Álvarez, B.R.; Gutiérrez, Y.; Valdés, V.S.; Parra, F. In vitro antiviral activity of Phyllanthus orbicularis extracts against herpes simplex virus type 1. Phytotherapy Res. 2003, 17, 980–982. [Google Scholar] [CrossRef]
- Ostrovskii, V.; Danagulyan, G.G.; Nesterova, O.M.; Pavlyukova, Y.N.; Tolstyakov, V.V.; Zarubina, O.S.; Slepukhin, P..; Esaulkova, Y.L.; Muryleva, A.; Zarubaev, V.V.; et al. Synthesis and antiviral activity of nonannulated tetrazolylpyrimidines. Chem. Heterocycl. Compd. 2021, 57, 448–454. [Google Scholar] [CrossRef]
- Burton, P.D.; Tezak, M. Variable Chain Length Carboxylic Acids as Modifiers to Enhance the Antiviral Efficacy of Sodium Dodecyl Sulfate; Sandia National Lab: Albuquerque, NM, USA, 2020. [Google Scholar] [CrossRef]
- Chirkov, S.N. The Antiviral Activity of Chitosan (Review). Appl. Biochem. Microbiol. 2002, 38, 1–8. [Google Scholar] [CrossRef]
- Peluso, G.; Petillo, O.; Ranieri, M.; Santin, M.; Ambrosic, L.; Calabró, D.; Avallone, B.; Balsamo, G. Chitosan-mediated stimulation of macrophage function. Biomaterials 1994, 15, 1215–1220. [Google Scholar] [CrossRef]
- Matica, M.A.; Aachmann, F.L.; Tøndervik, A.; Sletta, H.; Ostafe, V. Chitosan as a Wound Dressing Starting Material: Antimicrobial Properties and Mode of Action. Int. J. Mol. Sci. 2019, 20, 5889. [Google Scholar] [CrossRef]
- Iriti, M.; Varoni, E.M. Chitosan-induced antiviral activity and innate immunity in plants. Environ. Sci. Pollut. Res. 2014, 22, 2935–2944. [Google Scholar] [CrossRef] [PubMed]
- Iriti, M.; Varoni, E.M. Chitosan-Elicited Plant Innate Immunity: Focus on Antiviral Activity. In Research Progress in Oligosaccharins; Springer: New York, NY, USA, 2016; pp. 65–81. [Google Scholar] [CrossRef]
- Dinculescu, D.; Gîjiu, C.L.; Apetroaei, M.R.; Isopescu, R.; Rău, I.; Schröder, V. Optimization of Chitosan Extraction Process from Rapana venosa Egg Capsules Waste Using Experimental Design. Materials 2023, 16, 525. [Google Scholar] [CrossRef]
- Frígols, B.; Martí, M.; Salesa, B.; Hernández-Oliver, C.; Aarstad, O.A.; Ulset, A.-S.T.; Sætrom, G.I.; Aachmann, F.L.; Serrano-Aroca, Á. Graphene oxide in zinc alginate films: Antibacterial activity, cytotoxicity, zinc release, water sorption/diffusion, wettability and opacity. PLoS ONE 2019, 14, e0212819. [Google Scholar] [CrossRef]
- Kropinski, A.M.; Mazzocco, A.; Waddell, T.E.; Lingohr, E.; Johnson, R.P. Enumeration of bacteriophages by double agar overlay plaque assay. In Bacteriophages; Methods in Molecular Biology; Humana Press: New York, NY, USA, 2009; Volume 501, pp. 69–76. [Google Scholar]
- Norgen Biotek Corporation. Total RNA Purification Kit. Available online: https://norgenbiotek.com/sites/default/files/resources/Total%20RNA%20Purification%20Kit%20Insert%20PI17200-34.pdf (accessed on 10 August 2021).

| Bacteriophage phi6 | Bacteriophage MS2 | ||||
|---|---|---|---|---|---|
| Control | Ch+Ac10 | Control | Ch+Ac10 | ||
| 30 min | PFU/mL | 4.96 × 107 ± 5.77 × 106 | 3.17 × 107 ± 1.37 × 107 | 4.33 × 106 ± 1.29 × 105 | 2.08 × 106 ± 6.35 × 105 |
| log reduction | - | 0.23 | - | 0.33 | |
| % inactivation virus | - | ≈0 | - | ≈0 | |
| 5 h | PFU/mL | 4.91 × 107 ± 1.50 × 107 | 2.14 × 106 ± 1.59 × 106 | 4.33 × 106 ± 1.29 × 105 | 2.77 × 105 ± 6.00 × 104 |
| log reduction | - | 1.47 | - | 1.20 | |
| % inactivation virus | - | 95.64 | - | 93.60 | |
| 24 h | PFU/mL | 5.12 × 106 ± 3.23 × 105 | 9.33 × 103 ± 9.45 × 103 | 4.33 × 106 ± 1.29 × 105 | 3.33 × 103 ± 1.15 × 103 |
| log reduction | - | 3.91 | - | 3.13 | |
| % inactivation virus | - | 99.98 | - | 99.92 | |
Disclaimer/Publisher’s Note: The statements, opinions and data contained in all publications are solely those of the individual author(s) and contributor(s) and not of MDPI and/or the editor(s). MDPI and/or the editor(s) disclaim responsibility for any injury to people or property resulting from any ideas, methods, instructions or products referred to in the content. |
© 2023 by the authors. Licensee MDPI, Basel, Switzerland. This article is an open access article distributed under the terms and conditions of the Creative Commons Attribution (CC BY) license (https://creativecommons.org/licenses/by/4.0/).
Share and Cite
Cano-Vicent, A.; Tuñón-Molina, A.; Martí, M.; Serrano-Aroca, Á. Biocompatible Chitosan Films Containing Acetic Acid Manifested Potent Antiviral Activity against Enveloped and Non-Enveloped Viruses. Int. J. Mol. Sci. 2023, 24, 12028. https://doi.org/10.3390/ijms241512028
Cano-Vicent A, Tuñón-Molina A, Martí M, Serrano-Aroca Á. Biocompatible Chitosan Films Containing Acetic Acid Manifested Potent Antiviral Activity against Enveloped and Non-Enveloped Viruses. International Journal of Molecular Sciences. 2023; 24(15):12028. https://doi.org/10.3390/ijms241512028
Chicago/Turabian StyleCano-Vicent, Alba, Alberto Tuñón-Molina, Miguel Martí, and Ángel Serrano-Aroca. 2023. "Biocompatible Chitosan Films Containing Acetic Acid Manifested Potent Antiviral Activity against Enveloped and Non-Enveloped Viruses" International Journal of Molecular Sciences 24, no. 15: 12028. https://doi.org/10.3390/ijms241512028
APA StyleCano-Vicent, A., Tuñón-Molina, A., Martí, M., & Serrano-Aroca, Á. (2023). Biocompatible Chitosan Films Containing Acetic Acid Manifested Potent Antiviral Activity against Enveloped and Non-Enveloped Viruses. International Journal of Molecular Sciences, 24(15), 12028. https://doi.org/10.3390/ijms241512028

